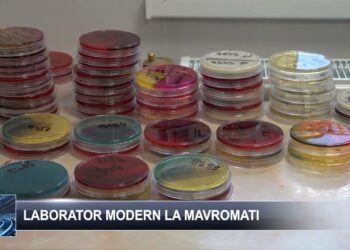
Laborator modern la Mavromati 10 octombrie 2024 TELE`M Botoșani

Pentru a oferi cea mai bună experiență, folosim tehnologii, cum ar fi cookie-uri, pentru a stoca și/sau accesa informațiile despre dispozitive. Consimțământul pentru aceste tehnologii ne permite să procesăm date, cum ar fi comportamentul de navigare sau ID-uri unice pe acest site. Dacă nu îți dai consimțământul sau îți retragi consimțământul dat poate avea afecte negative asupra unor anumite funcționalități și funcții.
Stocarea tehnică sau accesul sunt strict necesare în scopul legitim de a permite utilizarea unui anumit serviciu cerut în mod explicit de către un abonat sau un utilizator sau în scopul exclusiv de a executa transmiterea unei comunicări printr-o rețea de comunicații electronice.
Stocarea tehnică sau accesul este necesară în scop legitim pentru stocarea preferințelor care nu sunt cerute de abonat sau utilizator.
Stocarea tehnică sau accesul care sunt utilizate exclusiv în scopuri statistice.
Stocarea tehnică sau accesul care sunt utilizate exclusiv în scopuri statistice anonime. Fără o citație, conformitatea voluntară din partea Furnizorului tău de servicii de internet sau înregistrările suplimentare de la o terță parte, informațiile stocate sau preluate numai în acest scop nu pot fi utilizate de obicei pentru a te identifica.
Stocarea tehnică sau accesul sunt necesare pentru a crea profiluri de utilizator pentru a trimite publicitate sau pentru a urmări utilizatorul pe un site web sau pe mai multe site-uri web în scopuri de marketing similare.